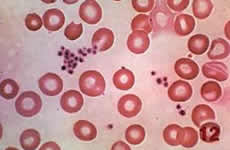

Plaquetas
Por Redação
As plaquetas são células do sangue, responsáveis pela coagulação do mesmo.
Elas são produzidas pela através da medula óssea, protegendo o ser humano de sangramento e hemorragias.
Uma pessoa com problemas na medula óssea, ou com alguma doença, como leucemia, câncer, anemia aplástica,
que prejudica a produção de plaquetas, ou que fazem ipedloucura1de quimioterapia ou radioterapia, corre perigo de ter hemorragias incontroláveis, que se não for feita uma transfusão, pode ocasionar a morte.
Essas pessoas que apresentam complicações na produção de plaquetas precisam receber transfusões frequentemente, até que o organismo volte a funcionar normalmente, fabricando suas plaquetas.

O fator RH e as tranfusões